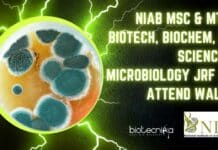
NIAB MSc & MTech Biotech, Biochem, Life Sciences & Microbiology JRF Job, Attend Walk-In NIAB MSc & MTech

IBAB Admission Open 2023 – M.Sc. In ‘Big Data Biology’ – Applications Invited
IBAB Big Data Biology MSc Admissions 2023 Open - Applications Invited
ADMISSION OPEN
M.Sc. in 'Big Data Biology'
The M.Sc. programme in Big Data Biology will be...
IISER Berhampur PhD Admission July 2023 For Biological Sciences
IISER Berhampur 2023 Admissions For PhD Biological Sciences
IISER Berhampur 2023 Admissions For PhD Biological Sciences. Biological Sciences PhD Admission July 2023 at IISER. IISER...
Govt NCT Delhi BSc Project Vacancy at ILBS – Biotech, Biochem, Life Sciences &...
BSc Project Vacancy at ILBS - Biotech, Biochem, Life Sciences & Microbiology Apply
BSc Project Vacancy at ILBS - Biotech, Biochem, Life Sciences & Microbiology...
Govt of Delhi ILBS Project Job For MSc Biotech, Biochem, Life Sciences & Microbiology
MSc Project Vacancy at ILBS - Biotech, Biochem, Life Sciences & Microbiology Apply
MSc Project Vacancy at ILBS - Biotech, Biochem, Life Sciences & Microbiology...
Freshers Graduate/Post Graduate Life Sciences QA Job at Avantor
Freshers Life Sciences Jobs at Avantor, Apply Online
Freshers Life Sciences Jobs at Avantor, Apply Online. Avantor Associate Global Quality Assurance Job, Life Sciences Apply...
JEET Research Scholarship 2023 Powered By Biotecnika – Applications Open
JEET Research Scholarship 2023 Powered By Biotecnika - Applications Open
Attention All Aspiring Scientists & Researchers!
Launching JEET Research SCHOLARSHIP +JEET BATCH
Join us for an intensive program designed...
10 PhD Positions Available at Marie Sklodowska-Curie Doctoral Network
10 PhD Positions Available at Marie Sklodowska-Curie Doctoral Network
Ten PhD positions are available in the Marie Sklodowska-Curie Doctoral Network “Chrom_rare: Unveiling the molecular basis...
Biotecnika Times Newsletter 10.04.2023 Himedia 0-1 Year Exp Job, THSTI Bioinformatics Jobs, Gene Mapping...
Biotecnika Times Newsletter 10.04.2023 Himedia 0-1 Year Exp Job, THSTI Bioinformatics Jobs, Gene Mapping Notes + Much More
HIMEDIA Bioinformatics Analyst Job For Candidates With...
Licious Food Science Job For BSc & MSc Candidates, Apply Via LinkedIn
Licious Food Science Job For BSc & MSc Candidates, Apply Via LinkedIn
Licious Food Science Job For BSc & MSc Candidates, Apply Via LinkedIn. Licious...
Givaudan Microbiology, Food Tech Quality Systems Specialist Job, Apply Online
Givaudan Microbiology, Food Tech Quality Systems Specialist Job, Apply Online
Givaudan Microbiology, Food Tech Quality Systems Specialist Job, Apply Online. University degree in Chemistry, Microbiology,...
Chittaranjan National Cancer Institute (CNCI) MSc Biology & Life Sciences JRF Jobs, Applications Invited
CNCI Biology JRF Jobs Opening - Life Sciences Can Also Apply
CNCI Biology JRF Jobs Opening - Life Sciences Can Also Apply. Chittaranjan National Cancer...
AIIMS Delhi SRF Job For MSc Biotech, Biochem, Life Sciences Candidates
AIIMS Delhi SRF Notification For MSc Biotech, Biochem & Life Sciences Candidates
AIIMS Delhi SRF Notification For MSc Biotech, Biochem & Life Sciences Candidates. AIIMS...
Syngene Clinical Flow Cytometry Job For MSc, MTech Biology, Biotech & Biochem Candidates
Syngene Clinical Flow Cytometry Job For MSc, MTech Biology, Biotech & Biochem Candidates
Syngene Clinical Flow Cytometry Job For MSc, MTech Biology, Biotech & Biochem...
NIAB MSc & MTech Biotech, Biochem, Life Sciences & Microbiology JRF Job, Attend Walk-In
NIAB MSc & MTech Biotech, Biochem, Life Sciences & Microbiology JRF Job, Attend Walk-In
NIAB Molecular Biology, Cell Culture Project JRF Job - Apply Online....
IISER Thiruvananthapuram MSc Programme 2023 Admissions Open For Biology
IISER Thiruvananthapuram MSc Admission 2023 Open For Biology
IISER Thiruvananthapuram MSc Admission 2023 Open For Biology. IISER Thiruvananthapuram Admissions MSc Programme 2023 For Biology. Interested...